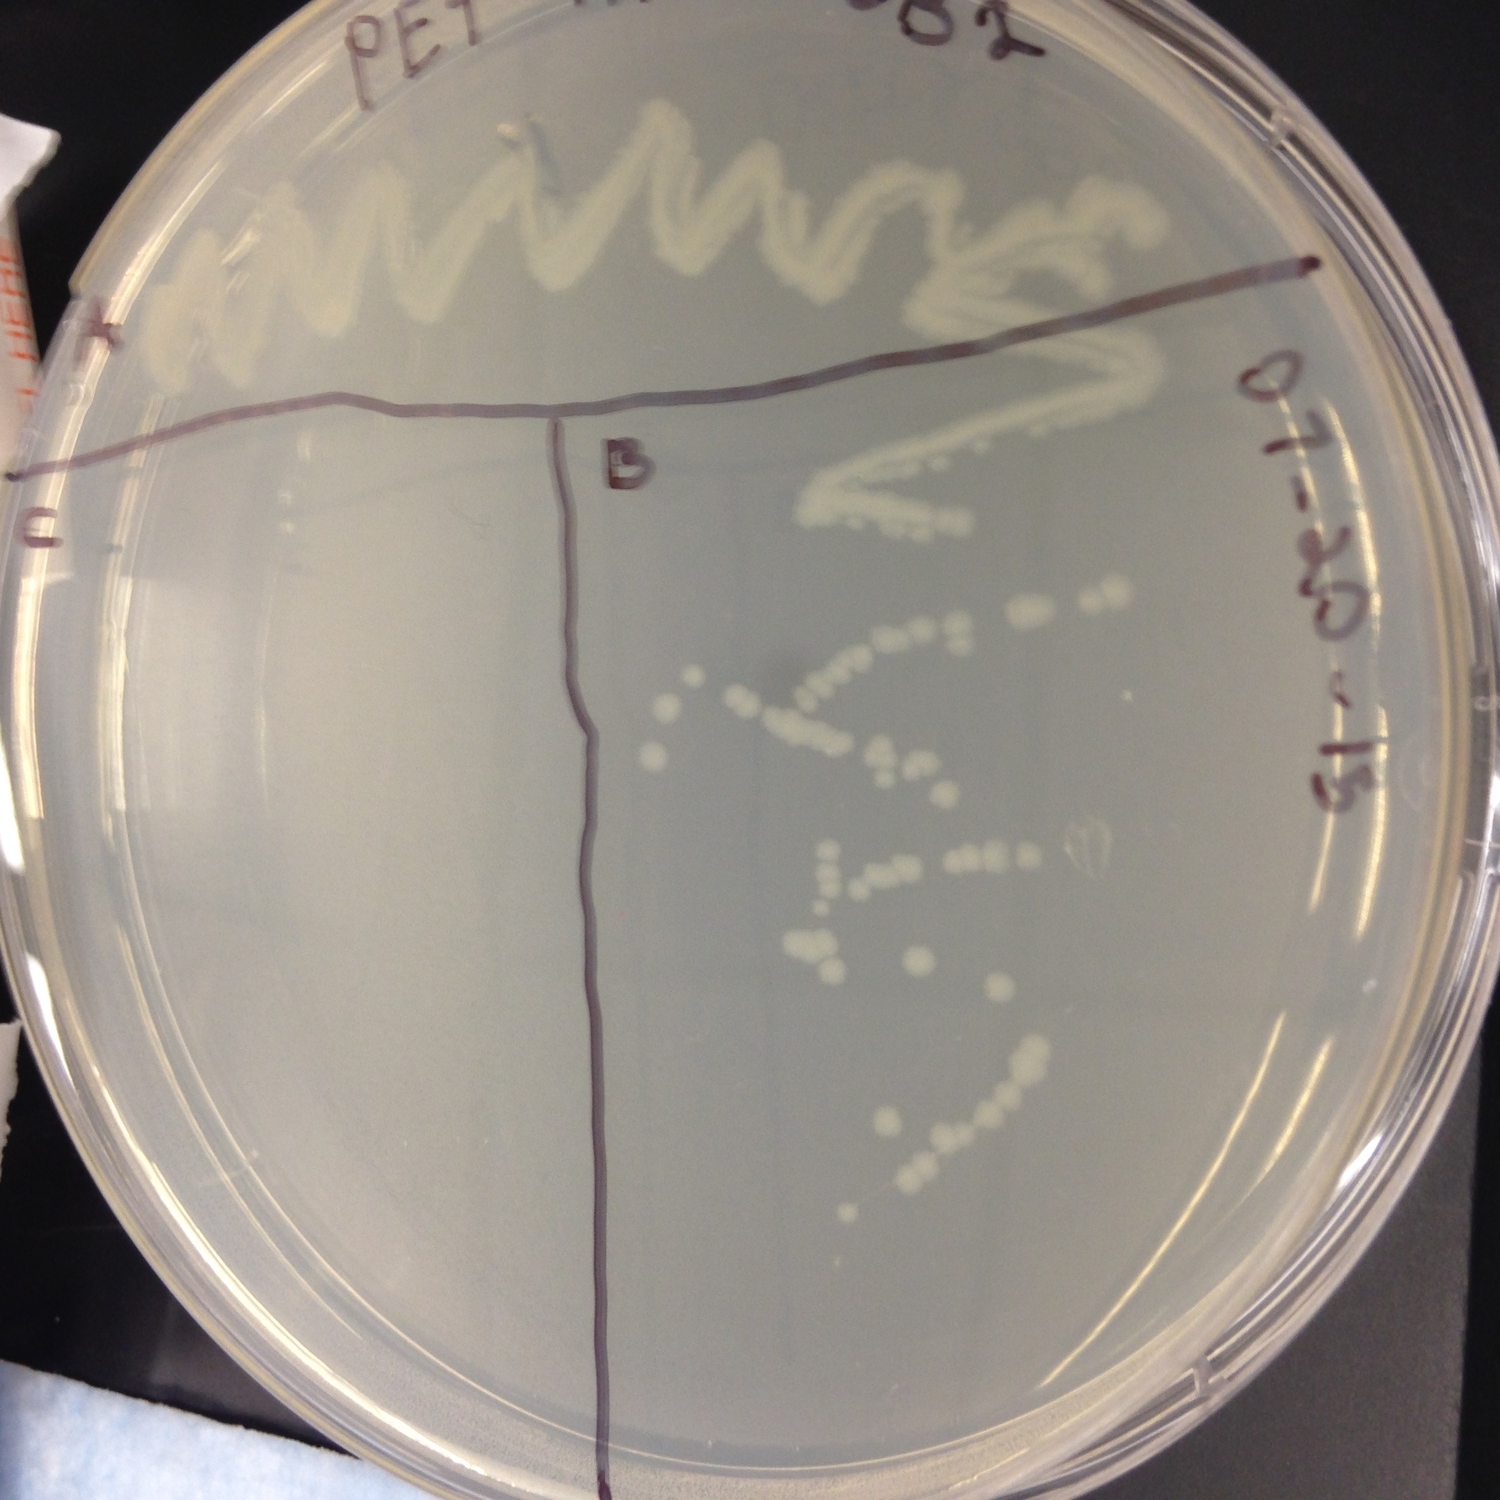
168.JPG
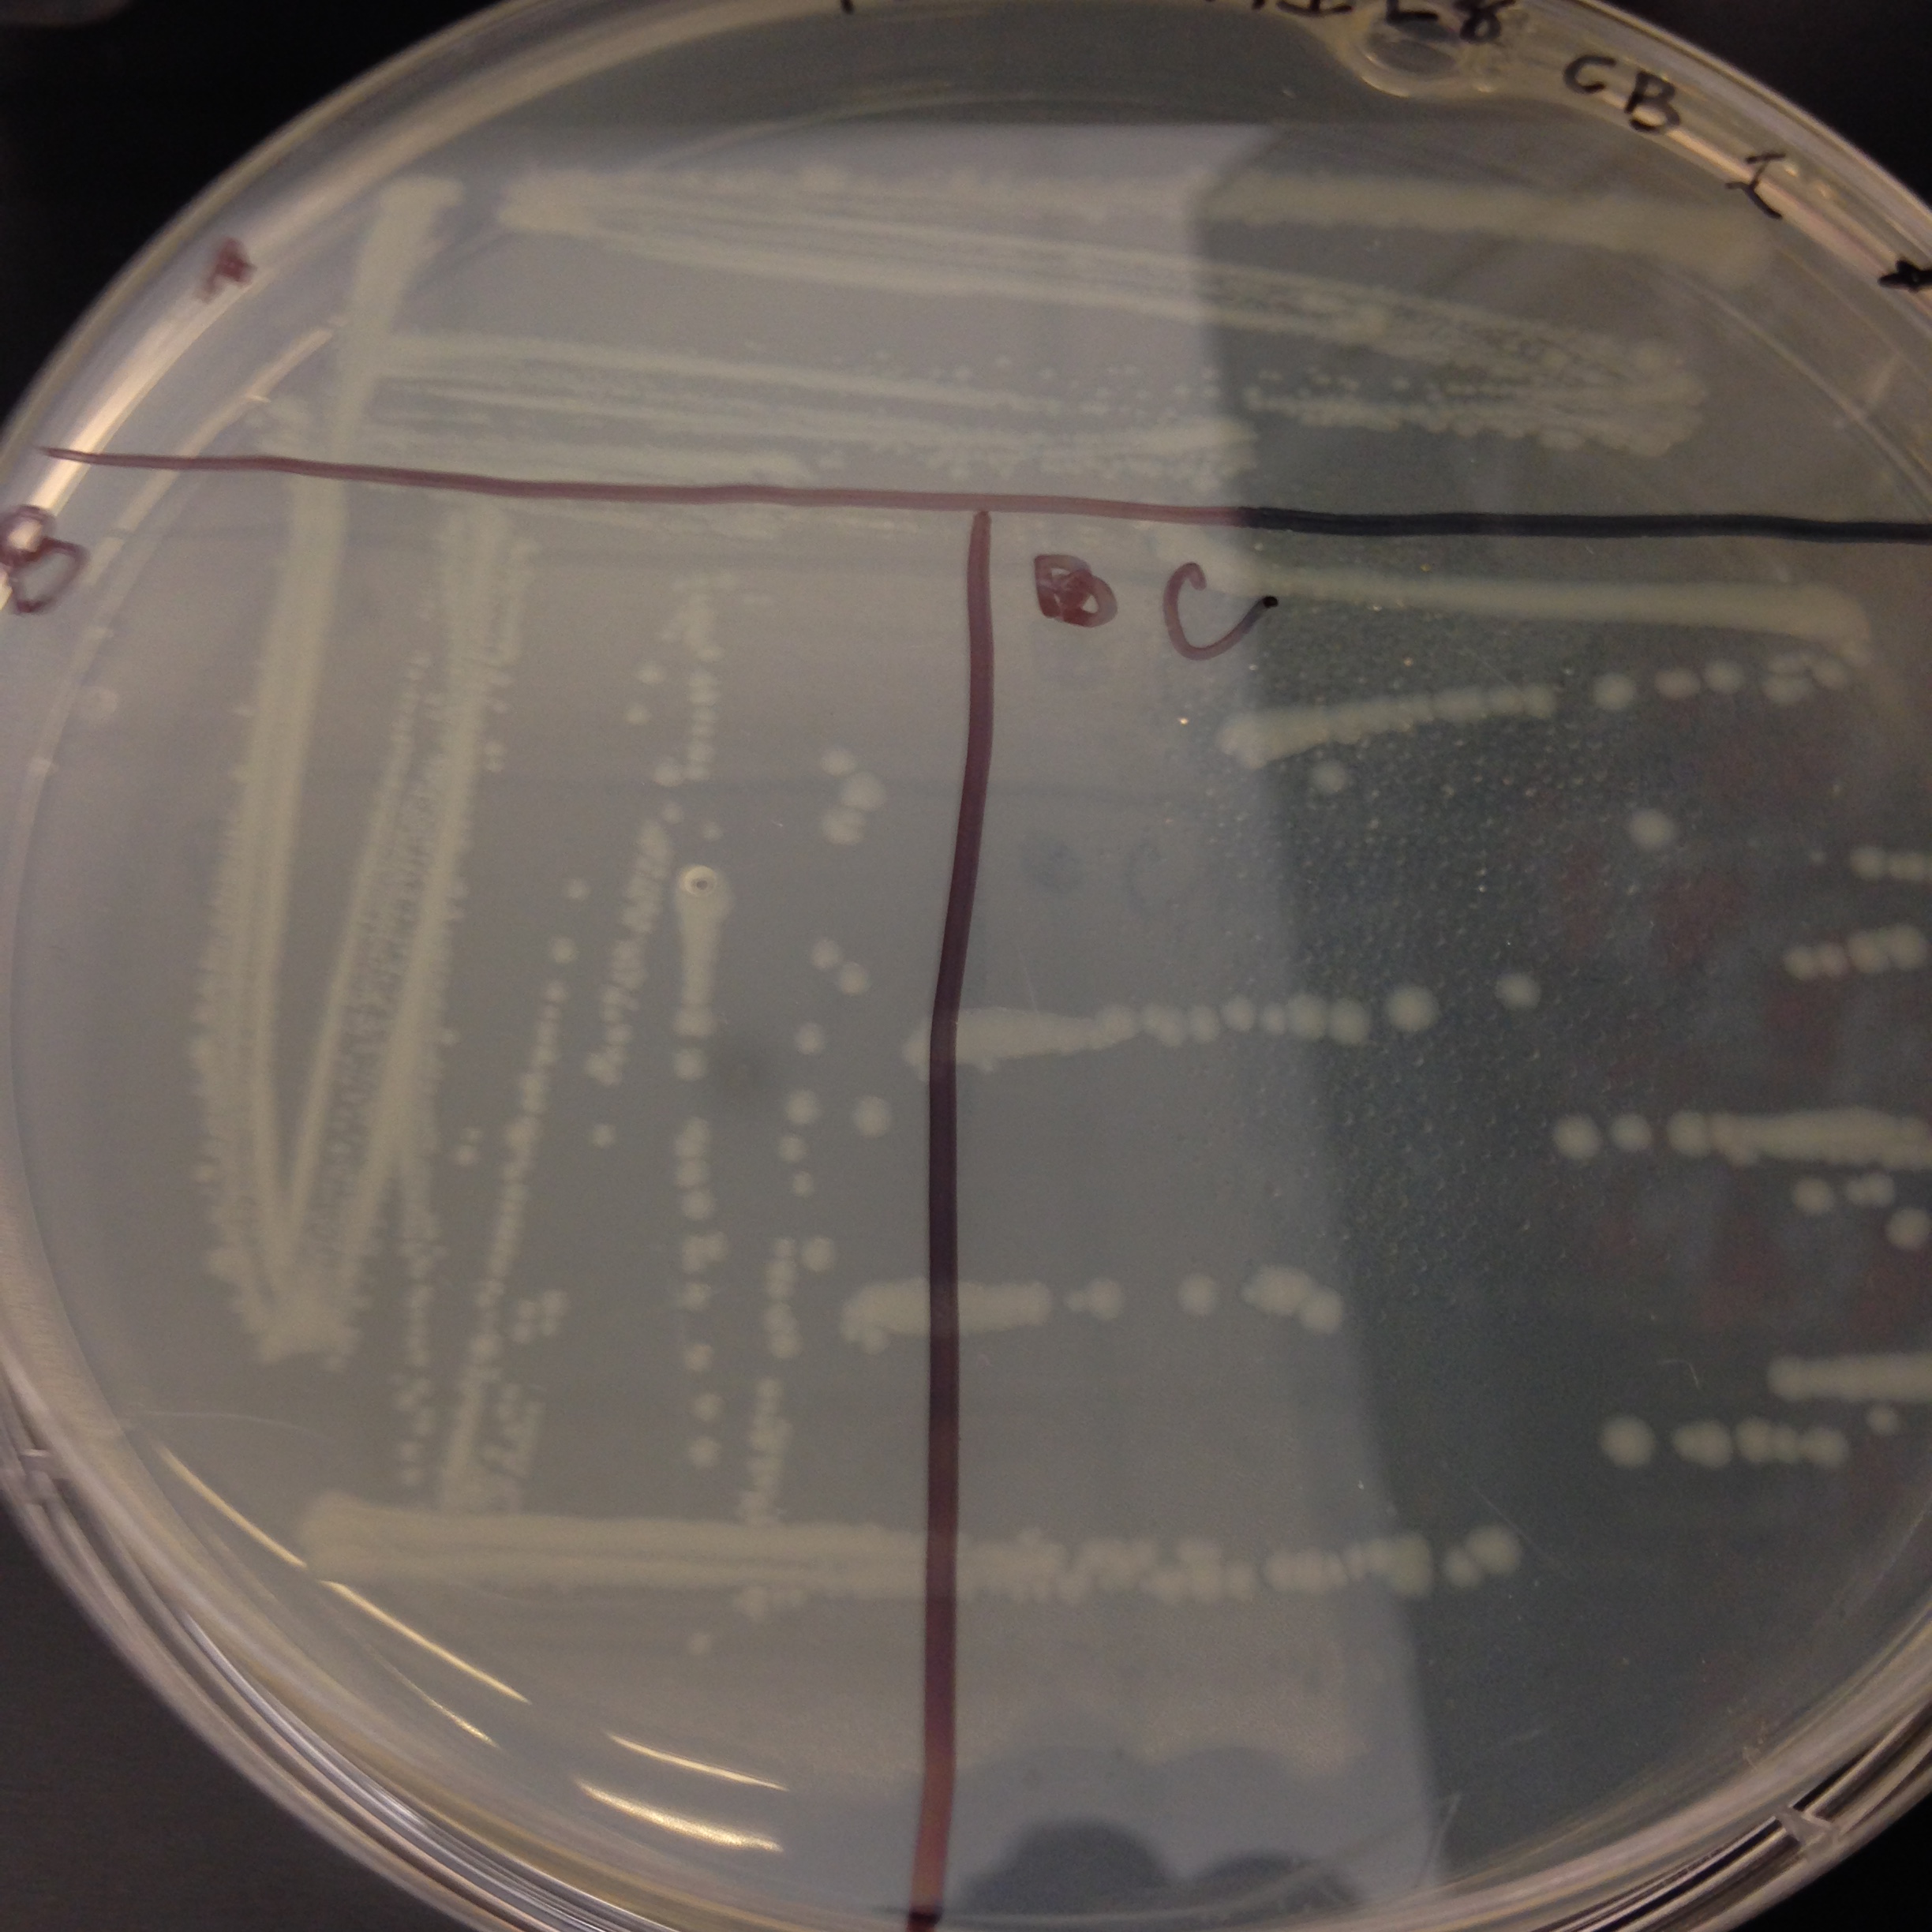
169.JPG
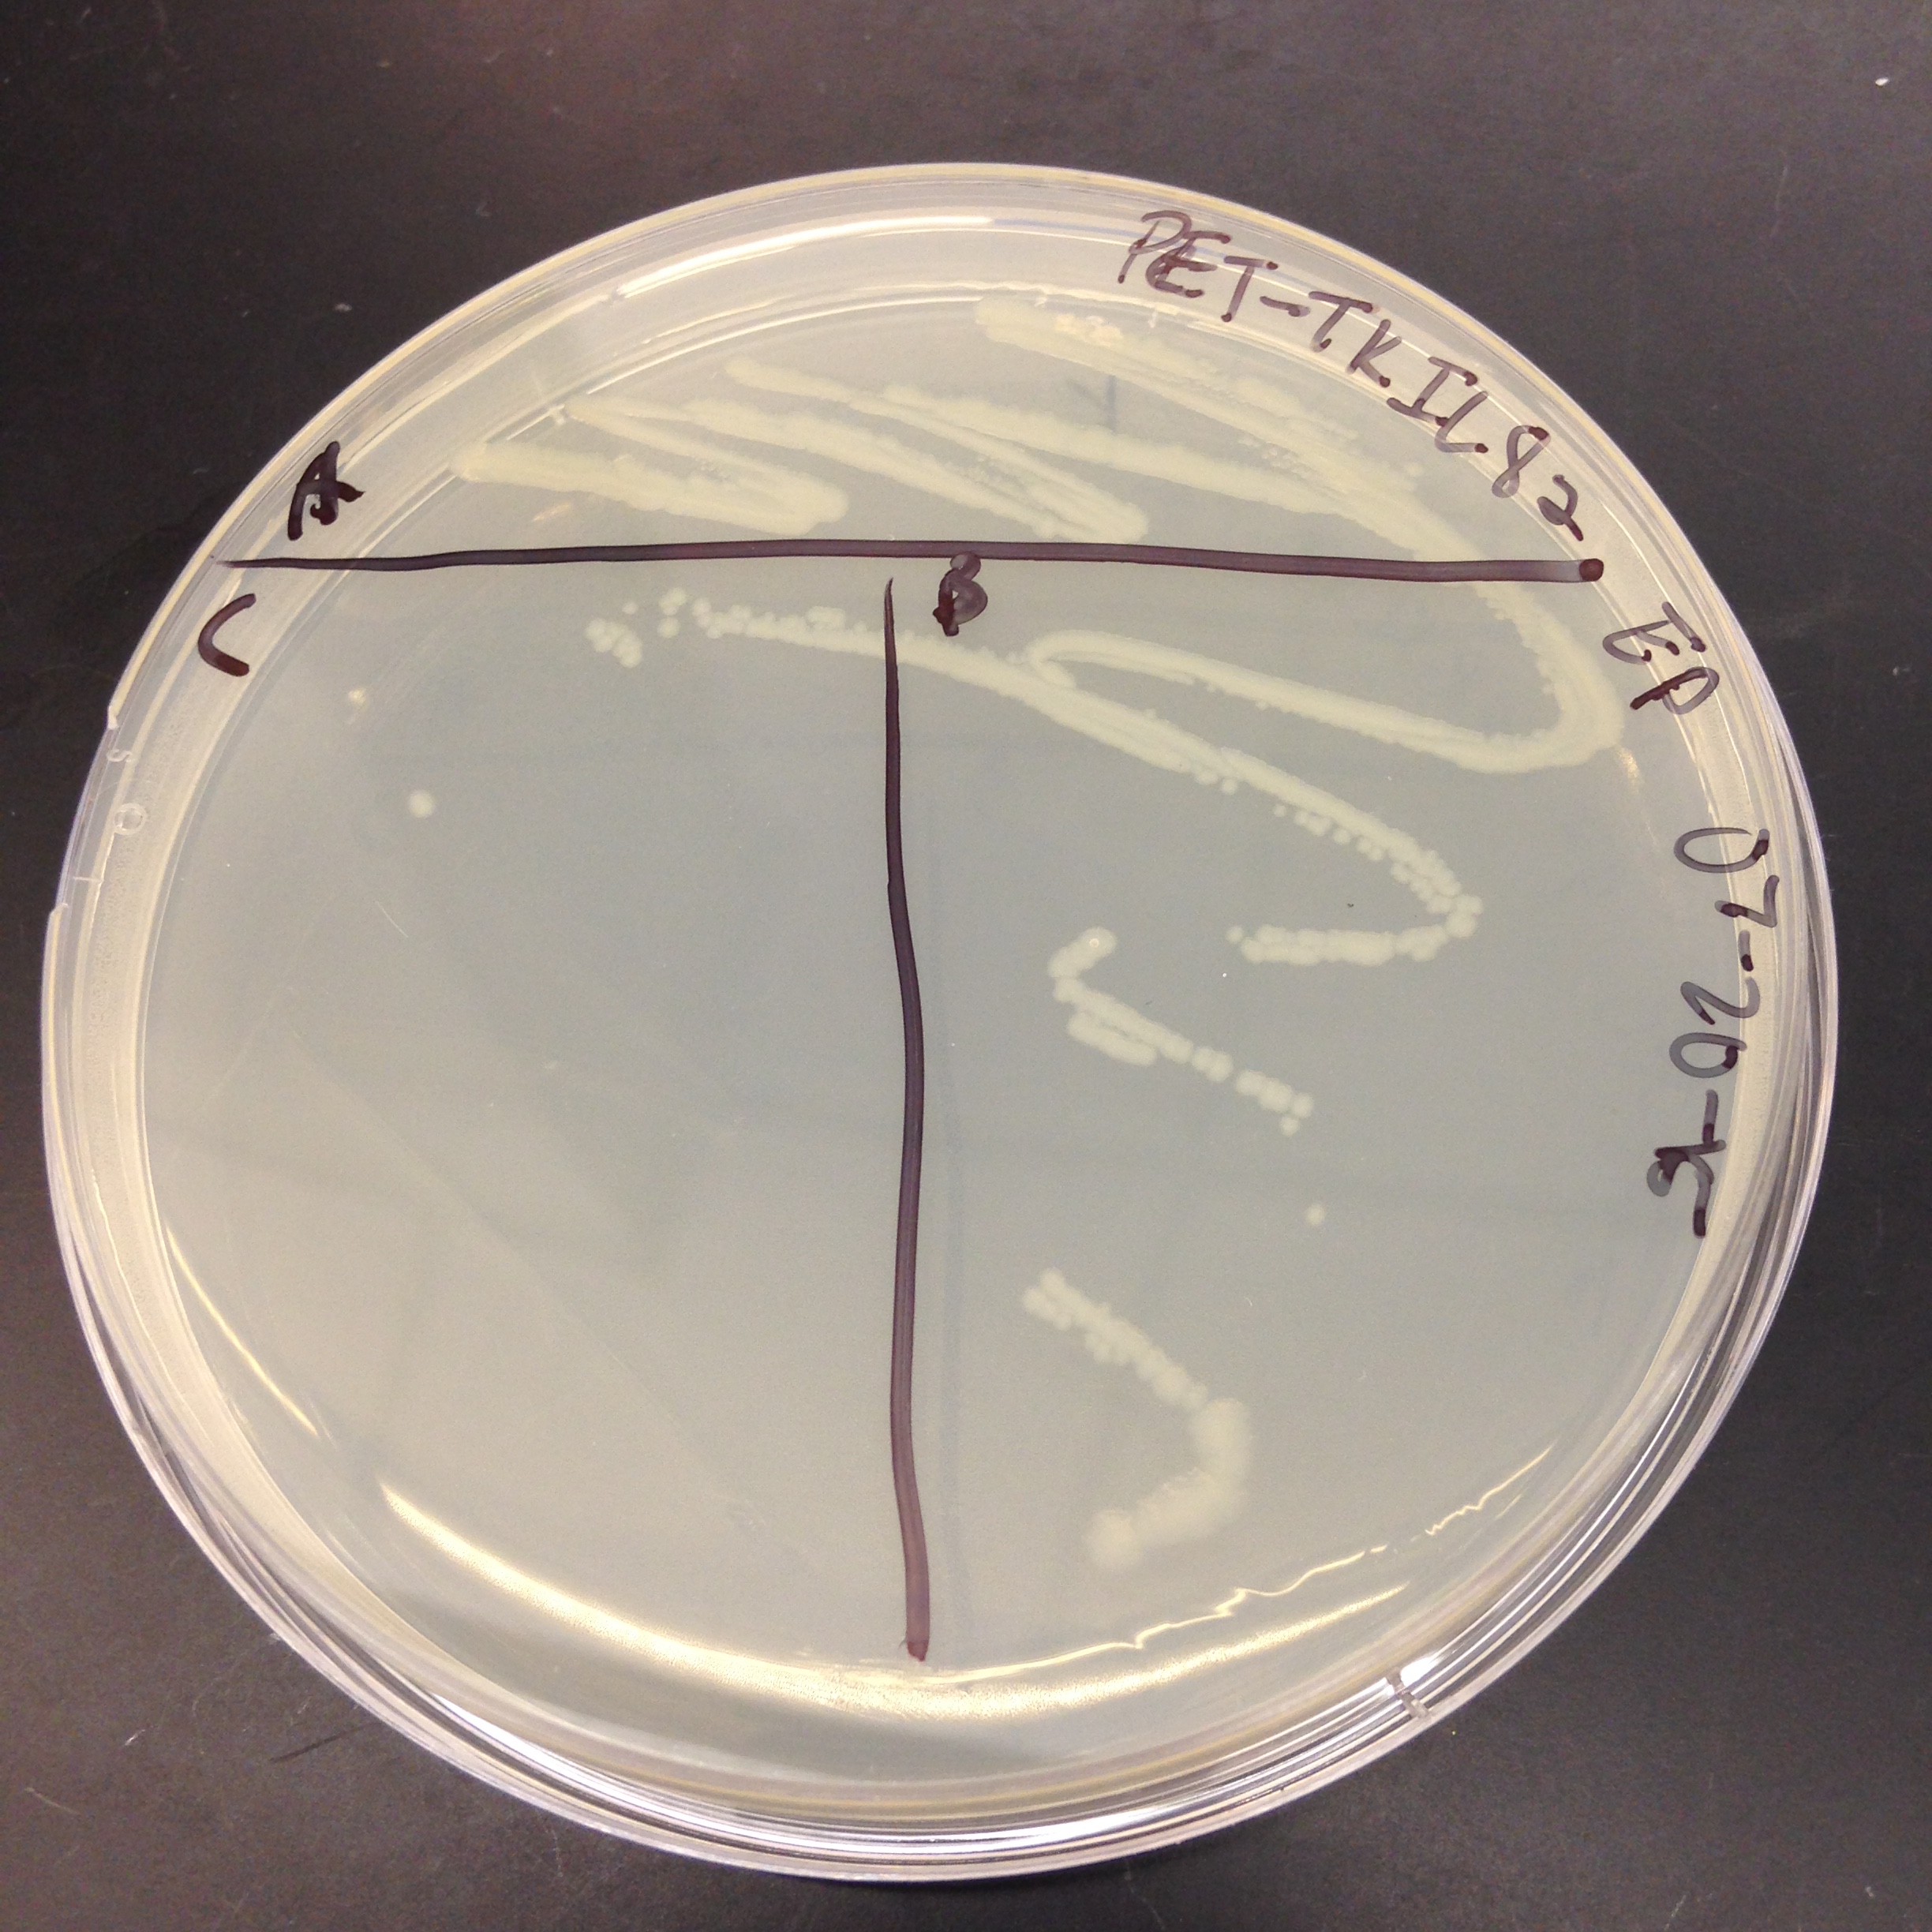
170.JPG

Falcon Biomanufacturing
ESTABLISHING A MODEL BIOTECHNOLOGY COMPANY IN A RURAL HIGH SCHOOL
OVER THE PAST 20 YEARS THE INDUSTRIES DRIVING OUR ECONOMY HAVE CHANGED. GOOD-PAYING LOW-SKILL JOBS ARE BEING REPLACED BY SCIENCE BASED HIGH-SKILLED JOBS. JOBS REQUIRING MORE TRAINING AND EDUCATION THAN HIGH SCHOOLS CURRENTLY PROVIDE. THIS SHIFT HAS FURTHER ALIENATED STUDENTS FROM RURAL AND UNDERSERVED COMMUNITIES. TO ENSURE THE CONTINUED GROWTH OF OUR ECONOMY, AND THE PARTICIPATION OF TALENT FROM ALL REGIONS AND BACKGROUNDS, NEW EDUCATIONAL APPROACHES MUST BE DEVELOPED TO PREPARE HIGH SCHOOL GRADUATES FOR THESE HIGH-SKILL JOBS.
BERTIE EARLY COLLEGE HIGH SCHOOL
The Bertie Early College High School (BECHS), located in Windsor, NC, was established in 2008 through a partnership with North Carolina New Schools, North Carolina State University, and Martin Community College. BECHS is a biotechnology and agriscience focused high school designed to provide students in this tier one community training in the skills for the 21st century. At BECHS students can earn an Associate in Arts Diploma, Associate in Arts Degree, or two years of college credit that can be transferred to a four-year college or university.
Over the past three years, and with the help of support from the NC State College of Agriculture and Life Sciences' Wynne Innovation Fund and the Burroughs Wellcome Fund's Student Science Enrichment Program, the students at BECHS have been learning how to clone, express, purify and validate recombinant proteins to be used in agricultural research being conducted at NC State.
The goal of this project is to establish a mini-biotech company, Falcon Biomanufacturing, in their biotechnology classroom. This biotech company will serve as an innovative teaching model to give students authentic learning experiences related to biology, chemistry, physics, and business elements of the NC Essential and Common Core Standards. This will help the students link these concepts through higher order thinking, and more importantly, link biotechnology and science to their daily lives and possible careers.
SUMMER BIOTECH BOOT CAMP
Working at NC State
Each year of the program starts with an intensive 5-day short course on biotechnology and protein expression held at NC State. While on campus, the students attend lectures and perform lab activities at the Biomanufacturing Teaching and Education Center (BTEC). The summer program introduces students to the scientific tools and techniques that are the core of their biotech company. The students learn that science, and the scientific method, are not just vocabulary words or subjects in school, but a discipline and an approach to answering questions. They learn how biotechnology is used everyday to make and improve the products they eat, wear and use.
Bacterial Lysis
The boot camp started off with the students learning about the difference between accuracy and precision, and tested their own ability to be accurate and precise by competing with Dr. Koci, Mr. Boller, and each other to demonstrate the lowest coefficient of variation when using micro pipettes. In addition to being precise the students learned about the importance of detailed record keeping and best practices for scientific notebooks.
After these introductory activities, the students conducted their first experiment to determine how different methods of physical lysis affect the efficiency of bacterial lysis, and how to determine the optimal lysis protocol for their process, using the bicinchoninic acid assay (BCA assay).
Western Blot
In order to confirm their E. coli cells expressed their protein of interest, the students learned how to conduct a Western Blot analysis using their different E. coli lysates. Using the total protein concentrations they determined for each lysate, they calculated the volume needed to load 10ug of protein onto each lane of a PAGE gel. The proteins were resolved and then transferred to nitrocellulose. The students then used a Nickel-HRP to probe their blots and detect the presence of their His-tagged recombinant protein. The students also assessed the relative difference in band intensity to the different lysis methods to further inform the best lysis approach.
Affinity Purification
After confirming the presence of their recombinant protein in their lysates, the students then used Nickel-His spin columns to affinity purify their protein. During this step the students learned the principles of affinity column purification. The students incubated their lysates with the affinity resin. Next they washed away all the unbound E. coli proteins using 10 1ml wash steps, collecting all the flow through for later analysis. Finally they collected their purified protein by eluting it from the column.
The students then took samples of their unbound flow through, column wash, and their eluted protein and performed another BCA assay to see how protein concentration changed over the course of the affinity purification step and determine how much purified protein they made.
BUILDING PARTNERSHIPS WITH INDUSTRY
While there have been considerable efforts to promote science, technology, engineering, and mathematics (STEM) in K-12 education over the past decade, these efforts still have not had a dramatic impact on the numbers of people pursuing STEM related careers. This has been especially true for students from rural and under served communities. One of the primary impediments to this is not intelligence or aptitude, but rather one of perception. Many students from rural and underserved communities believe that science and science-based careers happen in other places. They don't have personal connections or know any one working in a STEM field and therefore can't see the their path to a STEM based career.
To address this, a key part of this program is to helps students make these connections. This starts during their week at NC State. Through a combination of field trips to various biotech companies in the RTP area as well as STEM professionals coming to visit with them on campus, the students begin developing informal mentoring relationships. Meeting STEM professionals with different backgrounds at biotech companies helps them develop the skills, including soft-skills, needed to be successful.
For the past three years 2 local Biotech Companies Novozymes and BioResource International (BRI) have opened up their doors to these great students. Scientists, engineers, and leadership at both of these two very different companies literally walk the students through how they screen, select, characterize, and then develop commercial applications. After the tours, the students have lunch with these STEM professionals and learn more about their backgrounds, where they went to school, what they majored in, how they came to work in biotech, and what they like about their jobs.
In addition to the STEM professionals they meet at these two companies, others came to them. Jamie Blackburn of SciMed Solutions, Fang Zhou of biopm visited with the students at BTEC to discuss how to be successful in business, soft-skills, presentations, creating LinkedIn profiles, and the importance of networking. They also met with Robin Clement, Colleen Vasu, and Brittany DesLauriers representing the College of Agriculture and Life Sciecnes, who talked to them about the transition from high school to college and ways to ensure they are successful.
Previous Visits to RTP
Falcon Biomanufacturing
After their week-long short course at NC State, the students are then tasked with translating the skills they learned to the biotechnology laboratory at BECHS. Most of the steps they learned do not fit neatly into a 90 min high school class block schedule. So the students need to figure out how to achieve the same results, with different tools, and different time constraints. This is no small task. To do this, the students work in small teams on individual components of each step in the process. And with the help of weekly Google Hangouts and monthly visits to BECHS by Dr. Koci and Mrs. Ali from NC State, the students evaluate their results, design experiments to further optimize and then cross-train the other teams once a method is established.
Each year's cohort has focused on a developing the expertise and standard operating procedures needed for a specific step, or technical method, of the protein production process.
At the end of the each school year, the Falcon Biomanufacturing students present posters based on their work at the BECHS Biotechnology Symposium.
Annual BECHS Biotechnology Symposium
National Science Conference
Each cohort year is capped off with a trip to a national level science conference where students get to meet, network, and learn from world-leading experts in biotechnology. The past 3 years the students have attended the annual meeting of the American Society for Microbiology.
Great Students Need Great Teachers
BECHS has a small student body, served by a small group of the best teachers in the eastern North Carolina. At the core of this project is Mr. Bruce Boller. Mr. Boller has been teaching high school science for over 30 years, with most of that time in Bertie County and is the instructor for Biotechnology I, II, III, and IV. Mr. Boller is a former Kenan Fellow, former Syngenta Summer Fellow, and the 2014 recipient of the NC Science, Mathematics, and Technology Education Center Outstanding 9-16 Educator Award.
Ultimate goal
At the end of this process we expect to have a student directed, sustainable model for authentic biotechnology education at the high school and early college level that can then be replicated in other Tier 1 communities across NC and the nation. This will ensure everyone can participate in STEM careers and compete for the high-skilled jobs of the 21st century regardless of where they live. Furthermore, society benefits by having the most diverse talent pool possible.
For more information about our project please contact Dr. Matt Koci (mdkoci@ncsu.edu) or Mr. Bruce Boller (bboller@bertie.k12.nc.us), or check back here for updates throughout the year.

![20150909_191054[1].jpg](https://images.squarespace-cdn.com/content/v1/53eac24ee4b0d09d9ab85644/1471660030163-5EGFNL6I8RW7UGHMIGDI/20150909_191054%5B1%5D.jpg)
![20150909_191140[1].jpg](https://images.squarespace-cdn.com/content/v1/53eac24ee4b0d09d9ab85644/1471660066091-V634BL79S2027X67SLAQ/20150909_191140%5B1%5D.jpg)









